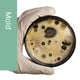
Allergy Test for Candida Albicans Allergy Mold Extract 10mL

Allergy Test for Candida Albicans Allergy Mold Extract 10mL
Year End Sale 24%
Original price
$ 785.95
Current price
$ 599.99
SKU 1239890
Hollister-Stier 5053 Allergy Testing for Candida Albicans Mold Allergy Extract 10mL bulk antigens.
Concentration Strength 1:10 w/v/ Multi-dose Vial
Composition/Ingredients: Glycerinated
Item: Allergy Extract
Type: Candida Albicans
Quantity: 10mL
Secondary Size: Vial
Volume: 10mL
Note:
* Special Order, Ships in 5 to 7 days.
* Not Returnable